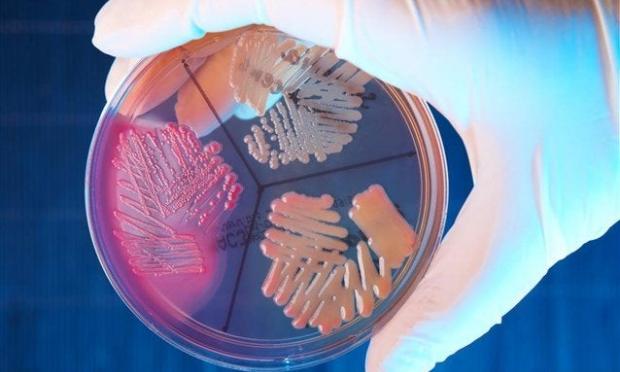

Τα βακτήρια που είναι ανθεκτικά στα αντιβιοτικά ευθύνονται για τον θάνατο 33.000 ανθρώπων το 2015 στην Ευρωπαϊκή Ένωση, σύμφωνα με τους υπολογισμούς Ευρωπαίων ερευνητών, που δημοσιεύονται από την επιθεώρηση The Lancet Infectious Diseases.
Από τα δεδομένα του ευρωπαϊκού δικτύου επιτήρησης EARS (European antimicrobia resistance surveillance network), οι ερευνητές εκπόνησαν ένα μοντέλο υπολογισμού των μολύνσεων και των θανάτων για πέντε τύπους λοιμώξεων.
Για το 2015 υπολογίζουν σε 671.689 τον αριθμό των προσώπων που μολύνθηκαν και σε 33.110 τον αριθμό των θανάτων που αποδίδονται στα πολυανθεκτικά βακτήρια.
Οι επιπτώσεις «είναι συγκρίσιμες με το συσσωρευμένο αποτέλεσμα της γρίπης, της φυματίωσης και του ιού του AIDS» κατά την ίδια περίοδο, επισημαίνουν οι ερευνητές.
Οι περισσότεροι από τους θανάτους αφορούν μωρά μικρότερα των 12 μηνών και τους άνω των 65 ετών. Οι επιπτώσεις σε όρους θνησιμότητας είναι πιο αυξημένες στην Ιταλία και την Ελλάδα. Η Ιταλία αριθμεί από μόνη της πάνω από το ένα τρίτο των θανάτων που συνδέονται με τα υπερβακτήρια, σύμφωνα με τη μελέτη.
Οι γιατροί προειδοποιούν τακτικά για τους κινδύνους από την υπερκατανάλωση αντιβιοτικών, με την οποία επικίνδυνα βακτήρια γίνονται ανθεκτικά.
Στο σύνολο των 670.000 λοιμώξεων από πολυανθεκτικά βακτήρια που υπολογίστηκαν για το 2015, σχεδόν τα δύο τρίτα σημειώθηκαν σε νοσοκομειακό περιβάλλον, επισημαίνουν οι ερευνητές.
Σύμφωνα με τη μελέτη, η Ιταλία και η Ελλάδα αντιπροσωπεύουν το ένα πέμπτο των λοιμώξεων.